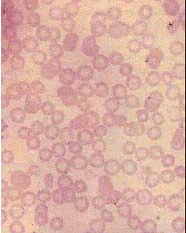

A.巨幼细胞贫血
B.再障
C.缺铁性贫血
D.慢性失血
E.急性失血
[多选题]某患者血涂片和骨髓涂片分别见图,该患者可能为()A.巨幼细胞贫血B.再障C.缺铁性贫血D.慢性失血E.急性失血
[多选题]某患者血涂片和骨髓涂片分别见图,该患者可能为()A.巨幼细胞贫血B.再障C.缺铁性贫血D.慢性失血E.急性失血
[多选题]某患者血涂片和骨髓涂片分别见图,该患者可能为()A.巨幼细胞贫血B.再障C.缺铁性贫血D.慢性失血E.急性失血
[多选题]某患者血涂片和骨髓涂片分别见图,该患者可能为()A.巨幼细胞贫血B.再障C.缺铁性贫血D.慢性失血E.急性失血
[多选题]某患者血涂片和骨髓涂片分别见图,该患者可能为()A.巨幼细胞贫血B.再障C.缺铁性贫血D.慢性失血E.急性失血
[多选题]某患者血涂片见图1,骨髓涂片见图2,该患者可能为()A.温抗体型自身免疫性溶血性贫血B.巨幼细胞贫血C.阵发性冷性血红蛋白尿症D.遗传性球形红细胞增多
[多选题]某患者血涂片见图1,骨髓涂片见图2,该患者可能为()A.温抗体型自身免疫性溶血性贫血B.巨幼细胞贫血C.阵发性冷性血红蛋白尿症D.遗传性球形红细胞增多
[多选题]某患者血涂片见图1,骨髓涂片见图2,该患者可能为()A.温抗体型自身免疫性溶血性贫血B.巨幼细胞贫血C.阵发性冷性血红蛋白尿症D.遗传性球形红细胞增多
[多选题]某患者血涂片见图1,骨髓涂片见图2,该患者可能为()A.温抗体型自身免疫性溶血性贫血B.巨幼细胞贫血C.阵发性冷性血红蛋白尿症D.遗传性球形红细胞增多
[多选题]某患者血涂片见图1,骨髓涂片见图2,该患者可能为()A.温抗体型自身免疫性溶血性贫血B.巨幼细胞贫血C.阵发性冷性血红蛋白尿症D.遗传性球形红细胞增多